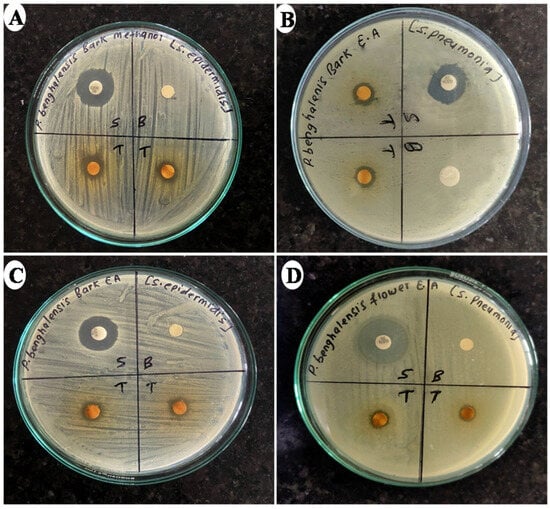
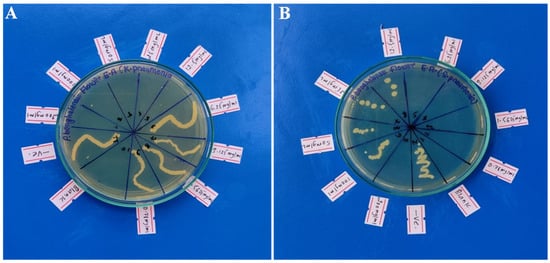

Abstract
This research is focused on assessing the antibacterial properties of Pogostemon benghalensis stem bark and inflorescence extracts, as well as their inhibitory effects on xanthine oxidase, antioxidant potential, overall phenolic content, and flavonoid concentration. The cold maceration technique was used to obtain extracts using water, methanol, and ethyl acetate solvents. The disk diffusion method demonstrated the significant antibacterial efficacy of the methanol stem bark extract against Staphylococcus epidermidis, with a zone of inhibition (ZOI) of 13 mm, and the inflorescence methanol extract against Klebsiella pneumonia (ZOI: 12.9 mm). Moreover, the methanol stem bark extract exhibited the minimum bactericidal concentration (MBC) at 1.56 mg/mL and the minimum inhibitory concentration (MIC) at 0.78 mg/mL against S. epidermidis. The ethyl acetate inflorescence extract displayed noteworthy xanthine oxidase inhibition (IC50: 29.1 µg/mL) comparable to allopurinol (IC50: 12.7 µg/mL). Furthermore, the methanol stem bark extract exhibited a remarkable DPPH free radical inhibitory effect, showing an IC50 value of 42.5 µg/mL. The total polyphenol content ranged from 29.9 μg to 161.3 µg GAE per mg of dried extract weight in the methanol inflorescence extract, while the total flavonoid content ranged from 38.4 μg to 96.8 μg QE per mg of dried extract weight within the water-derived extract. Overall, these findings demonstrate the potent antibacterial properties, xanthine oxidase inhibition, and antioxidant activity of P. benghalensis extracts.
1. Introduction
For thousands of years, natural substances like herbs, minerals, and animal products have been essential in disease treatment, with Ayurveda documenting their use for around 5000 years. Historically, plants and microorganisms have yielded effective medicines, aiding in the fight against numerous diseases [1,2]. The ongoing search for potent therapeutics from natural sources remains central to pharmaceutical research, leveraging herbal resources and disease models in cells, animals, and humans for major advances [3,4]. The vast array of medicinal plants and their diverse secondary metabolites continues to support the discovery of new agents for combating modern diseases [5,6]. Despite advancements in modern medicine, unequal access, side effects, high costs, and a preference for natural treatments drive research into herbal medicines [7,8,9,10]. Rising antibiotic resistance has spurred bacterial strains that are increasingly tolerant to current drugs, leading to higher morbidity and mortality due to the lack of effective treatments and the high costs of next-generation antibiotics [11,12]. This urgent situation encourages exploring plant-based materials for potent antimicrobial agents, aiming to identify therapeutic compounds and develop new drug candidates [13].
Xanthine oxidase (XO) is a widely distributed enzyme that participates in the conversion of purine bases, and its excessive production is associated with gout development [14,15]. The treatment of gout primarily focuses on increasing the elimination of uric acid or reducing its production [16,17,18]. Drug molecules, such as allopurinol, uricosuric agents, corticosteroids, and NSAIDs, are commonly used for gout management. Uricase enzymes offer potential advantages but face obstacles due to antibody susceptibility [19,20]. Xanthine oxidase (XO) inhibitors are increasingly attractive due to their reduced side effect profile compared to alternative agents. Allopurinol stands out as the primary XO inhibitor in clinical use despite its related adverse effects. Seeking other anti-gout treatments without undesirable effects, researchers have explored various plant species known for their traditional use in treating gout and arthritis [21,22].
Pogostemon benghalensis (Burm.f.) Kuntze, belonging to the Lamiaceae family, is a compact perennial shrub with a height ranging from 1 to 2 m (Figure 1) [23]. It is indigenous to the Himalayan region and can be found at altitudes ranging from 150 to 1300 m [24]. This plant is commonly found in India, Nepal, Pakistan, and Bangladesh. In Nepal, it is known by the popular name “Rudilo” [25]. It is a fragrant plant that contains a significant number of essential oils, particularly in its fresh leaves and inflorescences. The plant’s inflorescences, leaves, roots, and stem bark are considered highly valuable components [26]. Various parts of plants are utilized in different formulations, such as decoctions, fresh extracts, poultices, and infusions, to address various health complications, including depression, infection, sexual debility, intermittent fever, and intestinal disorders [25,26]. In the case of snake bites, a paste made from fresh roots and soft leaves is applied topically. Additionally, the fresh juice extracted from the roots and leaves is known to show effectiveness in addressing different health conditions, such as cold, malaria, hemorrhage, pneumonia, food poisoning, tuberculosis, cough, vomiting, and respiratory tract infections [26,27]. Aromatic essential oils extracted from the inflorescences and leaves are commonly used for massage to alleviate body aches, inflammation, and arthritis pain [28,29]. In rural areas of Nepal, the decoction made from the entire plant is utilized to treat typhoid fever [26,30]. In addition to the traditional medicinal uses attributed to it, the P. benghalensis plant has been investigated in numerous scientific studies that have demonstrated its diverse range of biological properties. These include antibacterial effects [31], antiviral properties [32], antioxidant activity [10,33], antifungal properties [26,34], anti-inflammatory effects [35], pain-relieving properties [25], fever-reducing properties [25], larvicidal activity [36], and potential anticancer activity [37]. Moreover, the leaves and inflorescences of P. benghalensis are abundant in essential oils, containing a rich array of phytochemicals such as phenolics, steroids, tannins, flavonoids, and various terpenes [25]. A GC-MS analysis of plant extracts and essential oil reveals bioactive monoterpenes, sesquiterpenes, and diterpenes, like β-bisabolene, α-pinene, linalool, β-caryophyllene, eicosane, n-hexadecenoic acid, and oleamide, which contribute to diverse pharmacological extract [25,26].

Figure 1.
(a) Fresh inflorescences of P. benghalensis; (b) shade-dried inflorescences of P. benghalensis; (c) dried stem barks of P. benghalensis peeled off from stems.
Traditionally, P. benghalensis has been used to treat various infections and inflammatory conditions, including skin infections, common colds, pneumonia, tuberculosis, and bacterial infections [26]. Although prior studies indicate anti-inflammatory and analgesic properties in the leaves and essential oils of P. benghalensis [25,35], its specific antibacterial potential in the inflorescence and stem bark, as well as its efficacy against the inflammatory disease gout, remain unexplored. This study aims to evaluate the antibacterial activity of P. benghalensis inflorescence and stem bark against Gram-negative and Gram-positive bacteria using the disk diffusion method, assess antioxidant potential via a DPPH assay, and investigate anti-gout activity through xanthine oxidase inhibition.
2. Materials and Methods
2.1. Chemicals Reagents, Solvents, and Standard Drugs
As part of this study, positive controls were included to assess antibacterial activity. Commercial antibiotic disks containing gentamicin and ciprofloxacin (from Microxpress, a division of Tulip Diagnostics Pvt. Ltd., York, UK) were employed for the reference standards in this regard. A variety of reagents from different sources were employed in this study, such as Mueller–Hinton agar (MHA) from HiMedia Laboratories Pvt. Ltd., Mumbai for antibacterial assays, DPPH (Thermo Fisher Scientific, India Pvt. Ltd., Mumbai, India) for the antioxidant activity assessment, 3(4,5-dimethylthiazol-2-yl)-2-5-diphenyl tetrazolium bromide (MTT) (Beyotime Biotechnology, Haimen, China) for the cell viability assessment, nutrient broth (HiMedia Laboratories Pvt. Ltd., Mumbai, India) for the bacterial culture, Folin–Ciocalteu reagent, ascorbic acid, dimethyl sulfoxide, and quercetin (Thermo Fisher Scientific, India Pvt. Ltd., Mumbai) for various biochemical assays, allopurinol (Himedia Laboratories Pvt. Ltd., Mumbai, India) as a reference standard, uric acid (S.D. Fine–chem. Limited, Mumbai, India) as a substrate, xanthine (Sigma Aldrich, St. Louis, MO, USA) and xanthine oxidase sourced from bovine milk, and barium chloride obtained from HiMedia Laboratories Pvt. Ltd., Mumbai for the evaluation of anti-gout activity.
2.2. Bacterial Strains Utilized in Study
To examine the in vitro antibacterial effectiveness of P. benghalensis inflorescence and stem bark extracts, eight bacterial strains were employed in this study: four Gram-positive bacteria, including Staphylococcus aureus ATCC 25923, Streptococcus pneumoniae ATCC 49619, Staphylococcus epidermidis ATCC 12228, and Bacillus cereus ATCC-154872, and four Gram-negative bacteria, namely, Escherichia coli ATCC 14948, Pseudomonas aeruginosa ATCC 15442, Klebsiella pneumoniae ATCC 4352, and Salmonella enteritidis ATCC-155350. All the strains of bacteria were obtained from Medicross Laboratory, Butwal, Nepal.
2.3. Authentication of Plant Sample
The inflorescence and stem bark of P. benghalensis (Figure 1b,c) were collected in April 2022 from Bhairahawa, Rupandehi, which is located in a tropical region at an elevation of 544 m above sea level. Fresh inflorescences, leaves, and an herbarium specimen of P. benghalensis were submitted to the National Herbarium and Plant Laboratory Godabhari, Nepal, for authentication (Reference number: 079/080/196). A validated herbarium specimen of P. benghalensis was stored in the pharmacognosy laboratory at Crimson College of Technology, Nepal (Herbarium number: CCT/HRB/2022-08).
2.4. Preparation of the Plant Extract
The gathered inflorescences and stems were initially washed using distilled water. Subsequently, the bark was carefully removed from each stem. The inflorescences and stem bark were then subjected to a drying process by placing them on sterile filter paper in a well-aerated lab environment, where they were allowed to dry for two weeks at 25 °C (Figure 1b,c). After the drying procedure, the dried inflorescences were manually crushed, while the bark was finely ground using a grinder. Subsequently, the ground materials were sieved through a mesh sieve with a mesh size of 40, ensuring a fine and uniform particle size. To ensure optimal extraction, a triple cold maceration method was used for all parts of the plant. In summary, 100 g of P. benghalensis inflorescence and stem bark were separately subjected to extraction in six conical flasks using 1000 mL of water, methanol, and ethyl acetate. The maceration process involved intermittent manual shaking every six hours for a duration of three days. After each maceration, the menstruum (liquid extract) was collected, and the marc (residue) underwent another round of extraction using fresh solvents in the same quantity. This process of maceration and extraction was repeated up to three times. Subsequently, all the filtrates were pooled together and dried with a rotary evaporator set at 40 °C to produce a concentrated gummy extract. The obtained extracts were then stored in a freezer at 4 °C for future use.
2.5. Calculation of Extractive Yield
The yield of extracts from P. benghalensis inflorescence and stem bark in water, ethyl acetate, and methanol was determined according to the following formula:
2.6. Quantitative Determination of Total Phenolic Content
The determination of the overall phenolic content in P. benghalensis inflorescence and stem bark extracts was performed utilizing the Folin–Ciocalteu (FC) technique, which is a widely recognized technique. Ethyl acetate, methanol, and aqueous extracts were utilized for this purpose. The experimental procedures were based on a previous research study, but with minor adjustments. To establish a standard calibration curve, six different concentrations of gallic acid were prepared using a stepwise serial dilution method in ethanol. Various samples were prepared in an ascending order of strength, ranging from 25 µg/mL to 800 µg/mL. For the preparation of plant extract solutions in ethyl acetate, methanol, and water, a concentration of 1 mg/mL was attained by utilizing ethanol as the solvent. Following this step, we precisely mixed 2 mL of the plant extract solution with 2 mL of the FC reagent in a glass test tube. Subsequently, 10 mL of water was added to the resulting mixture. The mixture solution was subjected to continuous stirring for a duration of 5 min. Subsequently, we introduced 2 mL of a 10% Na2CO3 solution into the test tube. The resulting mixture was then allowed to incubate at room temperature for an approximate duration of 1 h. The absorbance of the reaction solution was ultimately recorded at 725 nm relative to a blank sample. The determination of phenolic content was conducted in three separate trials, and the total phenolic content (TPC) was reported as μg gallic acid equivalent (GAE)/mg of dry extracts based on the gallic acid calibration curve. [38].
2.7. Quantitative Determination of Total Flavonoid Content
To assess the total flavonoid content in the extracts of P. benghalensis inflorescence and stem bark obtained through ethyl acetate, methanol, and water, a widely recognized technique utilizing aluminum chloride (AlCl3) was utilized. The quantification procedure employed in this study was derived from a previous research article, with appropriate adjustments. In order to establish a standard calibration curve, a stepwise serial dilution method was employed to create six distinct concentrations of quercetin, which were dissolved in ethanol. The concentrations were prepared in an ascending order of strength, ranging from 25 µg/mL to 800 µg/mL. For the preparation of plant extract solutions in ethyl acetate, acetone, methanol, and water, a concentration of 1 mg/mL was attained by utilizing ethanol as the solvent. Following this step, 2 mL of the plant extract solution was combined with 8 mL of distilled water in a glass test tube. In the subsequent step, we introduced 0.6 mL of a solution containing 5% NaNO2 to the mixture. The resulting mixture was subjected to continuous agitation for a duration of 5 min. Following this step, we added 0.6 mL of a solution containing 10% AlCl3 to the mixture. The resulting mixture was then incubated for a period of 5 min. Subsequently, 4 mL of 1 M NaOH was introduced to the mixture. The final combination was then allowed to incubate at room temperature for an approximate duration of 30 min. A similar procedure was carried out to prepare a blank sample, with the only difference being the use of 2 mL of ethanol (the solvent) instead of the plant sample solution. Following this step, all the standard, plant sample, and blank solutions underwent analysis using a UV spectrophotometer (UV-1800 model; Shimdazu Corporation Pvt. Ltd., Shanghai, China), specifically, at a precise wavelength of 510 nm. In order to ensure accurate and reliable measurements, the analysis was conducted in triplicate for each solution [38].
2.8. Evaluation of Antioxidant Activity
For the evaluation of the antioxidant strength of P. benghalensis ethyl acetate, methanol, and aqueous extracts, a commonly employed method involving 1,1-diphenyl-2-picrylhydrazyl (DPPH) free radical scavenging was chosen. The experimental methodology utilized in this study was derived from a previously published research article, with minor adaptations made to suit our specific needs. A solution of DPPH with a concentration of 0.1 mM was prepared using ethanol as the solvent. Likewise, stock solutions of standard ascorbic acid (100 µg/mL) and plant extract (1 mg/mL) were prepared using the same solvent as the diluent. Following this step, we prepared four distinct concentrations of ascorbic acid solutions (12.5 µg/mL, 6.25 µg/mL, 3.125 µg/mL, and 1.5620 µg/mL) through dilution. Additionally, seven different concentrations of concentrations were prepared in an ascending order of strength, ranging from 500 µg/mL to 7.81 µg/mL, utilizing the serial dilution technique. To initiate the free radical scavenging reaction, a volume of 5 mL of DPPH solution was carefully transferred into a glass test tube. Subsequently, 5 mL of the plant extract solution was added to the same tube. The reaction was conducted individually for each diluted plant extract and standard sample in separate tubes. Following thorough mixing, the resulting mixture solutions were incubated for approximately 30 min while being shielded from light to maintain optimal conditions. The extent of DPPH free radical scavenging by different concentrations of plant extract samples was evaluated by measuring the absorbance of the plant extract–DPPH solutions using a UV spectrophotometer set to a wavelength of 517 nm. Ethanol was utilized as the control blank, while the ascorbic acid solution served as the positive control. Each measurement was repeated three times to ensure accuracy and consistency. The inhibition percentage of free radicals by each plant extract sample was determined using the following equation.
Percentage radical scavenged = [(A0 − AS)/A0] × 100%
The calculation of the percentage of inhibited free radicals is based on the absorbance values, where A0 represents the absorbance of the blank control and AS represents the absorbance observed for the DPPH–plant mixture. Furthermore, the IC50 value, which signifies the concentration of the sample in μg/mL necessary to neutralize 50% of DPPH free radicals, was determined by conducting a logarithmic regression analysis and interpolating the data acquired from various concentrations of the plant extract.
2.9. Xanthine Oxidase Inhibitory Assay of P. benghalensis Inflorescence and Stem Bark Extracts
In order to investigate the anti-gout activity of dried inflorescence and stem bark extract from P. benghalensis, an in vitro assay targeting xanthine oxidase inhibition was performed using a spectrophotometric method [39,40,41,42].
2.9.1. Preparation of Plant Extract, Xanthine, Xanthine Oxidase (XO) Solution
To begin with, a xanthine solution was prepared by dissolving xanthine in a small quantity of NaOH to achieve a concentration of 0.15 mM while ensuring a pH level of 7.5. The xanthine oxidase solution was prepared with a concentration of 0.2 units/mL, and its pH was optimized to 7.5 using a 50 mM potassium phosphate buffer. In a similar manner, we created four different concentrations of the test and standard samples (400, 200, 100, and 40 µg/mL) by employing serial dilution techniques in a 50 mM potassium phosphate buffer at a pH level of 7.5.
2.9.2. Xanthine Oxidase Inhibition Activity Assay
In order to achieve final concentrations of 10, 25, 50, and 100 µg/mL, we combined 0.25 mL of standard and test solutions from four different concentrations (400, 200, 100, and 40 µg/mL) with 0.375 mL of xanthine solution and an equal volume of 50 mM phosphate buffer (pH 7.5). To initiate the chemical reaction, 0.035 mL of XO solution was added, and the mixture was incubated at a temperature of 25 °C for a period of 10 min. The reaction was stopped by the addition of 0.1 mL of a 1 M HCl solution. Afterward, the absorbance change was measured at a wavelength of 295 nm using a UV-visible spectrophotometer. To establish the baseline and control, allopurinol was used as the standard sample, while phosphate buffer served as the blank sample. Every experiment was performed in triplicate, ensuring reliable and consistent results. The percentage of xanthine oxidase inhibition was calculated using the following formula:
In the given equation, A0 represents the initial absorbance of the enzyme solution without any test material, while A1 signifies the absorbance of the enzyme solution in the presence of the test sample.
2.10. Evaluation of the Antibacterial Effect of P. benghalensis Inflorescence and Stem Bark Extracts
2.10.1. Plant Extracts and Filter Paper Disk Preparation
To prepare six different solutions of P. benghalensis extract for antimicrobial assay, 50 mg of each extract was carefully placed into individual vials and thoroughly mixed with 0.5 mL of dimethyl sulfoxide (DMSO) to ensure complete dissolution and uniformity. Consequently, each 10 µL of the plant extract solution prepared contained a concentration of 1 mg of dry extract. Using a punching machine, circular filter paper disks with a diameter of 5 mm were carefully extracted from Whatman’s No. 1 filter paper. Afterward, the disks were sterilized in an autoclave at a temperature of 115 °C for a period of 15 min to ensure complete sterilization [42].
2.10.2. Sub-Culturing Bacterial Strains and Muller–Hinton Agar (MHA) Preparation
The widely recognized disk diffusion method was utilized in this study to evaluate the antimicrobial efficacy of P. benghalensis inflorescence and stem bark extracts obtained from ethyl acetate, methanol, and aqueous solvents. In order to prepare the growth medium, a precise amount of 19 g of Mueller–Hinton agar (MHA) powder was meticulously dissolved in 500 mL of distilled water. The resultant solution underwent thorough mixing within a conical flask, ensuring proper homogeneity. To preserve its sterility, the flask was securely sealed using a clean cotton plug. To avoid possible containment, the conical flask was encased with aluminum foil. To sterilize the media solution, the prepared flask was then positioned inside an autoclave, subject to the prescribed temperature (121 °C) and pressure (15 lbs) for a duration of 15 min, following standard protocols. Under aseptic laminar airflow conditions, the sterilized media was subsequently cooled to a temperature within the range of 40–50 °C. Afterward, the media was aseptically transferred into numerous sterile Petri dishes, allowing it to settle. Among these Petri dishes, two were chosen randomly to investigate any potential microbial contamination. The designated plates were subjected to incubation for a duration of 24 h at a steady temperature of 37 °C. The remaining Petri dishes were stored in a refrigerator set at 5 °C, ensuring their preservation. In order to carry out sub-culturing of the ATCC bacterial strains, a sterile inoculating loop was subjected to heat using a Bunsen burner and subsequently allowed to cool down. Following that, the cooled loop was immersed into individual tubes containing bacterial suspensions. Using the inoculating loop, each specific bacterial strain was evenly streaked in a zigzag manner across the surface of a sterile Petri dish filled with MHA media. A grand total of eight unique bacterial strains were subcultured onto distinct Petri dishes, which were meticulously labeled accordingly. Subsequently, these Petri dishes were placed in an incubator set at a temperature of 37 °C for a period of 24 h to promote bacterial proliferation. Throughout the entire duration of the experiment, the utmost care was taken to maintain a completely sterile and aseptic environment. This was achieved by consistently implementing laminar airflow techniques [42].
2.10.3. Bacterial Inocula/Suspension Preparation
To initiate the procedure, nutrient broth media was meticulously prepared and subjected to sterilization. Afterward, 5 mL of the sterilized broth media was carefully and hygienically transferred into eight separate test tubes, with each tube specifically labeled to correspond to the respective bacterial strain being studied. Subsequently, employing a sterilized inoculating loop, the specific bacterial strains from the subcultured Petri dishes were carefully introduced into their corresponding test tubes containing the broth media. This meticulous process was conducted under strict aseptic conditions to ensure the integrity of the experiment. Lastly, the aseptic test tubes of S. aureus, B. cereus, S. pneumoniae, S. epidermidis, K. pneumonia, S. enteritidis, E. coli, and P. aeruginosa were carefully moved to an incubator and maintained at a consistent temperature of 37 °C. The test tubes were incubated for a duration of 24 h, providing ample time for the bacterial colonies to proliferate and develop. The optical density of each bacterial suspension was subsequently evaluated in comparison to a 0.5 McFarland standard solution, and necessary adjustments were made to attain the desired level [43].
2.10.4. Calculation of the Zone of Inhibition (ZOI) Against Examined Bacterial Strains
To investigate the antibacterial potency of P. benghalensis inflorescence and stem bark extracts against a set of eight pathogenic bacterial strains, the zone of inhibition (ZOI) was assessed and measured in millimeters (mm). This measurement served as a means to determine the extent of bacterial growth inhibition caused by the extracts. To carry out this examination, sterile cotton applicators were immersed in separate tubes containing bacterial suspensions. Subsequently, the applicators were spread evenly across the entirety of individual sterilized Petri dishes containing MHA media, ensuring complete coverage. Several Petri plates were readied for every bacterial strain according to the quantity of samples slated for analysis. Each Petri dish harboring the inoculated bacteria was distinctly marked with the corresponding name of the bacterium for clear identification purposes. The described process was subsequently replicated for the remaining seven distinct bacterial strains, following the same methodology. After concluding the bacterial inoculation, every Petri dish was partitioned into approximately equal quadrants. Within each quadrant, both commercially available standard antibiotic disks (10 μg drug/ disk) and self-prepared filter paper disks were positioned at equidistant intervals from one another. The sterile filter paper disks were impregnated with 10 µL of either the plant extract or a blank control solution, as illustrated in Figure 2. In the case of the blank control, a consistent volume of 10 µL of DMSO was applied to the aseptic filter disk. All experiments were carried out in triplicate to ensure accuracy and reliability. Following that, the Petri dishes containing the samples were placed in an incubator set at a temperature of 37 °C for a duration of 24 h. On the next day, the extent of bacterial growth inhibition caused by the plant extracts and standard antibiotic disks under investigation was precisely assessed by measuring the affected area using a Vernier caliper [42].
Figure 2.
Photographs depicting ZOIs produced by different extracts of P. benghalensis stem bark and inflorescence against different bacterial strains ((A) methanol stem bark extract against S. epidemidis; (B) ethyl acetate stem bark extract against S. pneumonia; (C) ethyl acetate stem bark extract against S. epidermidis, and (D) ethyl acetate inflorescence extract against S. pneumonia).
2.10.5. Determination of MBC and MIC Values
To ascertain the minimum bactericidal concentration (MBC) and minimum inhibitory concentration (MIC) of P. benghalensis inflorescence and stem bark extracts against the eight pathogenic bacterial strains, a well-established twofold serial broth microdilution technique was chosen for the analysis. A set of 11 small-sized test tubes was subjected to sterilization and subsequently labeled in a clear and distinct manner for each extract. Among these, nine test tubes were specifically allocated for the diluted extract solutions, while one test tube was designated as the blank control, and another was designated as the negative control. With the aid of a micropipette, a precise volume of 1.5 mL of sterile MHA broth media was carefully dispensed into every individual tube. Nine sterile test tubes were accurately labeled accordingly to generate nine distinct diluted concentrations of the extract solution. In the initial test tube, a stock solution was meticulously formulated by combining 400 mg of the extract with 2 mL DMSO (200 mg extract/mL). Following this step, a series of consecutive half dilutions were conducted using a diluent consisting of a homogeneous blend of DMSO and water in equal proportions. As a result of this procedure, nine distinct dilutions were generated, encompassing a concentration range from 200 mg/mL to 0.78125 mg/mL. Following that, a precise volume of 500 µL of the plant extract solution was carefully introduced into the corresponding broth media tubes, leading to the formation of nine separate solutions consisting of plant extract and broth media. These solutions exhibited concentrations ranging from 50 mg/mL to 0.1953125 mg/mL, which were achieved through a fourfold dilution. Furthermore, every vial received a bacterial inoculum consisting of approximately 1 × 105 colony-forming units per milliliter (CFU/mL). Before transferring the inoculum into the test tubes, the density of each bacterial suspension was calibrated to correspond with the 0.5 McFarland standards by adjusting its turbidity. The 10th tube was administered 500 µL of diluent and functioned as a blank control to confirm the media sterility. Similarly, the 11th tube was exclusively subjected to the bacterial inoculum, serving as a negative control to ascertain the appropriateness of the broth media for bacterial cultivation. Following this step, all the specimens were introduced into an incubation chamber set at a constant temperature of 37 °C for a period of 24 h. After this designated incubation interval, the minimum inhibitory concentration (MIC) value of the six extracts against the eight diverse bacteria was determined. The MIC was established as the most minimal concentration of the plant extract solution that completely impeded bacterial growth in the respective test tube. In order to evaluate the survivability of bacterial cells, the compound 3-(4,5-dimethylthiazol-2-yl)-2,5-diphenyl tetrazolium bromide (MTT) was employed. Following the initial incubation, the samples underwent an additional 2 h incubation period at 37 °C, facilitating the interaction between the MTT compound and viable bacterial cells. Subsequently, a visual inspection was conducted to observe the formation of formazan, which served as an indicator of bacterial metabolic activity [42,43].
For the determination of the MBC, sterile MHA Petri dishes were prepared and activated by subjecting them to an incubation period of 45 min at a temperature of 37 °C without the presence of any bacteria. Following this step, the Petri dishes were moved to a sterile room outfitted with a dedicated laminar airflow system to ensure an uninterrupted flow of purified air. Subsequently, aliquots from each appropriately diluted test tube, which were prepared using the same methodology employed during the MIC evaluation, were inoculated onto the activated MHA plates for sub-culturing. The subcultured media were subsequently relocated to an incubator and maintained at a consistent temperature of 37 °C for a duration of 24 h. Ultimately, the MBC was established as the most minimal concentration of the plant extract sample that entirely prevented bacterial growth on the surface of the culture media [42,43].
2.11. Statistical Analysis
Each measurement was conducted in triplicate, and the outcomes were presented as the mean ± standard deviation (SD). For the analysis of the total phenol and flavonoid content, the significance of disparities between the various groups was calculated by utilizing one-way ANOVA, followed by Tukey’s test. Similarly, for the analysis of the antioxidant effect, the Pearson correlation coefficient (r) was computed to find the linearity of the relation between the dose of the extract and the DPPH scavenged percentage. The statistical significance of the Pearson correlation was determined by calculating the p-value using a two-tailed t-test.
3. Results
3.1. Extractive Yield Value
The extractive yield of six different extracts of P. benghalensis inflorescence and stem bark obtained from ethyl acetate, methanol, and water are given in Table 1. According to the data presented in Table 1, the percentage yield of plant extracts varies between 2.8% and 6.4%. The extractive yield or extraction rate quantifies the extractable material in a plant sample, indicating extraction efficiency. A higher extraction rate suggests optimal recovery of bioactive compounds and allows for the comparison of solvent efficacy, techniques, or sample types for maximizing phytochemical recovery [44,45,46]. Among the three examined solvents, the extraction rate was highest in the ethyl acetate extract for inflorescence, whereas the bark had the highest extraction ratio in methanol. Several studies on P. benghalensis have reported that the inflorescence and leaves of this plant are rich in non-polar phytoconstituents like monoterpenes, fatty acids, and diterpenoids. These compounds can be extracted more efficiently by non-polar solvent ethyl acetate [44,45]. Similarly, methanol is ideal for extracting bioactive compounds from plant bark due to its polarity, which dissolves diverse phytochemicals like phenolics and flavonoids, disrupts hydrogen bonding, enhances solubility, and improves yield while preserving compound integrity [46,47].

Table 1.
Results of extractive yield obtained from the ethyl acetate, methanol, and aqueous extracts of P. benghalensis inflorescence and stem bark.
3.2. Quantitative Analysis of Total Phenol Content
In our investigation, the quantitative determination of the overall phenolic content was accomplished by employing the Folin–Ciocalteu reagent. The outcomes were expressed as µg of gallic acid equivalent (GAE) per milligram of the dry extracts (Table 2). As shown in Table 2, considerable disparities were noted in the total phenolic content across the six distinct extracts, with measurements ranging from 29.9 ± 2.4 μg GAE/mg of dry extract weight for the aqueous inflorescence extract to 161.3 ± 1.7 μg GAE/mg of dry extract weight for the methanol inflorescence extract.

Table 2.
Results of the total flavonoid and phenol content from six different extracts of P. benghalensis inflorescence and stem bark.
3.3. Quantitative Analysis of Total Flavonoid Content
Within our investigation, we performed a comprehensive quantitative analysis of six distinct extracts obtained from the inflorescences and stem bark of P. benghalensis. The primary objective was to ascertain the overall content of flavonoids present in these extracts. The findings were presented as micrograms of quercetin equivalent (QE) per milligram of dry extract. The outcomes pertaining to the overall flavonoid content in the different extracts can be observed in Table 2. As shown in Table 2, considerable disparities were noted in the total flavonoid content across the six distinct extracts, with measurements ranging from 38.4 ± 2.6 μg QE/mg of dry extract weight for the aqueous inflorescence extract to 96.8 ± 1.6 μg QE/mg of dry extract weight for the methanol inflorescence extract.
3.4. Quantitative Measurement of Antioxidant Activity by Utilizing the DPPH Free Radical Inhibition Method
According to the data presented in Table 3, our results demonstrate that the methanol bark extract exhibited the highest degree of inhibition against DPPH free radicals, displaying an impressive efficacy of 93.4% at a concentration of 500 µg/mL. In contrast, the bark ethyl acetate extract demonstrated the lowest level of free radical inhibition, with only 4.9% observed at a concentration of 15.625 µg/mL.

Table 3.
Results for the DPPH free radical scavenging effect of P. benghalensis inflorescence and stem bark extracted in ethyl acetate, methanol, and water.
Figure 3 presents the IC50 values for the various extracts, along with ascorbic acid, serving as a metric to depict their efficacy in inhibiting free radicals. Among the six distinct extracts, the methanol inflorescence extract exhibited the most favorable IC50 value (42.5 µg/mL). Conversely, the aqueous inflorescence and stem bark extracts were unable to achieve a 50% inhibition of DPPH radicals within the tested concentrations. In contrast, the reference compound ascorbic acid exhibited an IC50 value of 5.2 µg/mL. The findings of this investigation indicate that extracts rich in flavonoids and phenolic compounds exhibited remarkable efficacy in scavenging free radicals. Additionally, Table 4 presents data regarding the DPPH free radical scavenging capacity demonstrated by the reference standard, ascorbic acid.

Figure 3.
Bar chart representing the IC50 values of four distinct extracts obtained from P. benghalensis inflorescence and stem bark in terms of DPPH free radical inhibition. The chart also includes the IC50 value of ascorbic acid for comparison. Abbreviations: (PBBEA: P. benghalensis bark ethyl acetate extract; PBBM: P. benghalensis bark methanol extract; PBFEA: P. benghalensis inflorescence ethyl acetate extract; PBFM: P. benghalensis inflorescence methanol extract; AA: ascorbic acid).

Table 4.
Results of the percentage of DPPH inhibition demonstrated by the reference standard, ascorbic acid, at various concentrations.
3.5. Evaluation of XO Inhibitory Effect of P. benghalensis Inflorescence and Stem Bark Extracts
In order to explore the potential anti-gout effect of P. benghalensis inflorescence and stem bark, an in vitro experiment was carried out. The experiment aimed to assess the inhibitory activity of ethyl acetate, methanol, and aqueous extracts of the inflorescence and stem bark against xanthine oxidase. Figure 4 illustrates the comparison of four distinct concentrations for each extract with the reference drug allopurinol. It was noted that all examined samples exhibited a concentration-dependent inhibitory effect on xanthine oxidase (XO). Among them, the ethyl acetate inflorescence extract displayed the highest XO inhibitory effect (80.0%) at a concentration of 100 µg/mL.

Figure 4.
Graphical representation illustrating the inhibitory effect of ethyl acetate, methanol, and aqueous extracts of P. benghalensis inflorescence and stem bark on XO activity at different concentrations, in comparison to the standard drug allopurinol. Abbreviations: (PBFEA: P. benghalensis inflorescence ethyl acetate extract; PBBEA: P. benghalensis bark ethyl acetate extract; PBFM: P. benghalensis inflorescence methanol extract; PBBA: P. benghalensis bark aqueous extract; PBBM: P. benghalensis bark methanol extract; PBFA: P. benghalensis inflorescence aqueous extract).
The IC50 value, indicating the concentration of the extract necessary to achieve a 50% inhibition of xanthine oxidase activity, was determined for each of the tested samples. Based on the data presented in Figure 5, it can be observed that the P. benghalensis ethyl acetate inflorescence extract showed a promising IC50 value of 29.10 µg/mL, comparable to the standard allopurinol (IC50-12.7 µg/mL), among the six tested extracts.

Figure 5.
Bar graph illustrating the IC50 values of six different extracts derived from P. benghalensis inflorescence and stem bark for inhibiting xanthine oxidase enzyme activity alongside the reference drug allopurinol. Abbreviations: (PBBEA: P. benghalensis bark ethyl acetate extract; PBBM: P. benghalensis bark methanol extract; PBBA: P. benghalensis bark aqueous extract; PBFEA: P. benghalensis inflorescence ethyl acetate extract; PBFM: P. benghalensis inflorescence methanol extract; PBFA: P. benghalensis inflorescence aqueous extract).
3.6. Screening of Antibacterial Potency of P. benghalensis Inflorescence and Stem Bark Extracts
According to the results presented in Table 5, the methanol extract of P. benghalensis stem bark demonstrated significant efficacy against S. epidermidis, with a zone of inhibition (ZOI) of 13.0 mm. However, it was ineffective against P. aeruginosa and S. enteritidis. Conversely, the ethyl acetate extract of stem bark exhibited notable inhibition (ZOI-11.7 mm) against the same bacteria. It is noteworthy that among the six extracts, only the ethyl acetate extract of P. benghalensis stem bark displayed measurable inhibition against all tested bacterial strains. In terms of Gram-negative strains, the methanol inflorescence extract of P. benghalensis showed prominent inhibitory effects against K. pneumoniae and E. coli, with ZOIs of 12.9 mm and 12.2 mm, respectively. Furthermore, S. epidermidis was found to be sensitive to all investigated extracts of P. benghalensis.

Table 5.
Results of the zone of inhibition against eight distinct pathogenic bacterial strains following exposure to the ethyl acetate, methanol, and aqueous extracts of P. benghalensis inflorescence and stem bark.
The results presented in Table 6 exhibit a diverse range of MIC values, spanning from 0.78 mg/mL to 25 mg/mL, along with MBC values ranging from 1.56 mg/mL to 50 mg/mL for the tested extracts. Out of all the extracts analyzed, the methanol extract obtained from the stem bark of P. benghalensis showcased remarkable effectiveness in combating S. epidermidis. This extract displayed an MIC value of 0.78 mg/mL and an MBC value of 1.56 mg/mL.

Table 6.
Results of the MIC and MBC values shown by six different extracts of P. benghalensis stem bark and inflorescence extracts against eight different pathogenic bacteria.
4. Discussion
The extraction of P. benghalensis inflorescence and stem bark in ethyl acetate, methanol, and water showed that the methanol inflorescence extract exhibited the highest percentage yield, while the aqueous extract of the inflorescence showed the minimal percentage yield. These findings reveal that the plant contains a substantial number of bioactive compounds, making it a promising source for isolating compounds with potential as lead molecules in the future for pharmaceutical development endeavors.
Plants are rich sources of polyphenols, compounds with one or more hydroxyl groups that effectively neutralize free radicals, establishing a direct relationship between antioxidant activity and polyphenolic content. Phenolic compounds, due to their hydrogen-donating ability, exhibit strong antioxidant properties [48]. Similarly, flavonoids, a diverse subgroup of polyphenols with multiple hydroxyl groups, contribute to antioxidant activity by donating hydrogen or electrons to stabilize free radicals [49]. As shown in Table 2, extraction efficiency for both phenolics and flavonoids is significantly influenced by the solvent type and plant part, with notable differences observed among extracts and plant parts (p < 0.05) in total phenolic and flavonoid content. Specifically, the methanolic extract from the inflorescence showed the highest total phenol and flavonoid content, while the aqueous inflorescence extract had the lowest. This study provides initial quantitative data on the phenolic and flavonoid content of P. benghalensis inflorescence and stem bark, while prior studies reported methanol extract showed phenolic and flavonoid contents for aerial parts, leaves, and roots at 169.43 [10], 32.31 [50], and 56.7 mg GAE/g [51] for phenolics, and 65.2, [10], 6.08 [50], and 34.00 mg QE/g [51] for flavonoids, respectively.
To assess the hydrogen- or electron-donating ability of plant extracts to neutralize DPPH free radicals, we measured changes in the color intensity of an ethanolic DPPH solution at 517 nm [52]. This study evaluated the scavenging capacity of six extracts from the inflorescence and stem bark of P. benghalensis by observing the absorbance reduction following the addition of each extract, indicating free radical neutralization. The methanolic inflorescence extract exhibited the strongest DPPH scavenging activity, with an IC50 of 42.5 µg/mL. This study provides initial quantitative data on the antioxidant activity of P. benghalensis inflorescence and stem bark. Previous studies reported IC50 values of 35.9 µg/mL [10] and 60.0 µg/mL [53] for the methanolic extracts from the aerial parts and roots, respectively, while a methanolic leaf extract from India showed 95.4% inhibition at 600.0 µg/mL [53]. Additionally, an ethanolic leaf extract demonstrated 81.4% inhibition at 150.0 µg/mL [54]. This analysis highlights the notable antioxidant efficacy of different extracts from P. benghalensis and confirms the influence of extract type and plant part on radical scavenging potential.
Our investigation of the xanthine oxidase inhibitory effect of P. benghalensis inflorescence and stem bark revealed the significant suppressive impact of the ethyl acetate-derived extract on xanthine oxidase activity in both inflorescence and stem bark extracts. This study provides quantitative data on the XO inhibitory effect of P. benghalensis inflorescence and stem bark for the first time. Extensive research has highlighted the presence of essential oils in the inflorescences, leaves, and stems of P. benghalensis, which comprise a wide range of active constituents, such as monoterpene, sesquiterpene, and diterpene derivatives, such as β-bisabolene, α-pinene, β-ocimene, p-cymene, γ-terpinene, linalol, β-elemene, borneol, α-humulene, germacrene D, β-caryophyllene, valencene, caryophyllene oxide, phytol, viridiflorol, spathulenol, and more [26,55,56]. Numerous studies have indicated that these terpenoids possess remarkable inhibitory effects against xanthine oxidase, highlighting their potential as promising agents in this regard [57,58,59,60,61]. Therefore, it is highly recommended that a systematic evaluation employing animal models be conducted, guided by bioassays, to delve deeper into the potential therapeutic effects of P. benghalensis inflorescence and stem bark extracts, for managing gout. Moreover, essential oils, which are non-polar in nature, are extracted to a higher extent in non-polar solvents like hexane, petroleum ether, and ethyl acetate [62,63]. This could explain why P. benghalensis ethyl acetate inflorescence and stem bark extracts exhibited the highest inhibitory effect on XO.
This investigation evaluated the antimicrobial efficacy of six distinct extracts from Pogostemon benghalensis inflorescence and stem bark against eight pathogenic bacterial strains—four Gram-positive and four Gram-negative strains, using 1.0 mg of dried extract per disk. Measurements of growth inhibition zones, obtained with a Vernier caliper, indicated that P. benghalensis extracts had a stronger effect on Gram-positive bacteria compared to Gram-negative strains (Table 5), which is likely due to the structural differences in bacterial cell walls. Gram-negative bacteria possess a drug-resistant lipopolysaccharide layer, while Gram-positive species feature a porous peptidoglycan layer, enhancing their susceptibility [64,65]. Notably, the inflorescence showed greater inhibition of Gram-negative bacteria compared to stem bark. Prior studies demonstrated that P. benghalensis methanol leaf extract inhibited S. aureus, K. pneumoniae, S. typhi, and E. coli (zones of inhibition, ZOI: 8–12 mm) [53], although the disk concentration was unspecified. An acetone leaf extract, at 5 mg per well, demonstrated the inhibition (ZOI: 20–22 mm) of S. aureus, P. aeruginosa, S. faecalis, and S. pyogenes, while essential oil from P. benghalensis leaves effectively inhibited B. megaterium, E. coli, and P. aeruginosa [34].
Moreover, in a recent study, the ethyl acetate extract of P. benghalensis leaves exhibited significant antimicrobial activity against both Gram-positive and Gram-negative bacteria. At a concentration of 80.0 μg, the extract produced growth inhibition zones of 13.0 mm for Staphylococcus aureus and Salmonella typhi and 15.0 mm for Klebsiella aerogenes and Enterococcus faecalis [44]. A GC-MS analysis of the leaf extract identified a range of bioactive compounds, including antibacterial monoterpenes and fatty acids, such as eicosane, n-hexadecenoic acid, oleamide, octadecane, 2-methyltetracosane, phytol, and cis-valerenyl acetate, which may contribute to the observed antimicrobial effects [44].
Among the 48 samples tested (comprising six distinct extracts individually evaluated against eight types of bacteria), 33 samples exhibited noticeable zones of inhibition (ZOIs). Subsequently, the investigation examined the MIC and MBC values of a total of 33 samples to find out the smallest concentration that inhibits bacterial growth and the concentration that kills bacteria, respectively, measured in mg/mL. As indicated in Table 6, the results show that among all six extracts tested, only S. epidermidis bacteria demonstrated sensitivity to both inhibitory and bactericidal effects at the concentrations studied. In relation to Gram-negative bacteria, the methanol extract derived from P. benghalensis inflorescence exhibited notable effectiveness against K. pneumonia and E. coli. It showed a minimum inhibitory concentration (MIC) of 1.56 mg/mL and a minimum bactericidal concentration (MBC) of 3.12 mg/mL for both bacterial strains. Similarly, Figure 6 depicts the MBC shown by the ethyl acetate extract of P. benghalensis inflorescence against two different bacterial strains. Although MIC and MBC analysis of P. benghalensis stem bark and inflorescence have not been reported yet, a similar study about MIC analysis of P. benghalensis leaves revealed that MIC values of its acetone extract against P. aeruginosa, S. faecalis, and S. aureus were 12.5, 25, and 50 mg/mL, respectively [66]. Major bioactive compounds present in P. benghalensis are phenolic compounds, monoterpene, sesquiterpene, diterpene, alkalois, saponin, and steroids [31,33,34]. These compounds have the ability to penetrate the bacterial cell wall and cytoplasmic membrane, disrupting their phospholipid, fatty acid, and polysaccharide layers. This disruption leads to changes in membrane potential, ion leakage, ATP depletion, and proton pump destruction. Ultimately, this damages the bacterial cell membrane, causing macromolecule leakage and cell lysis [67].
Figure 6.
Pictures depicting MBC shown by ethyl acetate extract of P. benghalensis inflorescence against two different bacteria ((A) against K. pneumonia; (B) against S. pneumonia).
5. Limitations of This Study
Although these findings provide valuable preliminary insights, they are constrained by several limitations. The absence of in vivo evaluations restricts our ability to assess the bioavailability, pharmacokinetics, and safety profile of the extracts in a physiological context. This study was further limited by the exclusive use of bacterial cell lines, which offers an incomplete understanding of the extract’s potential impacts in more complex biological systems that may involve host immune responses and other interactions. Additionally, we were unable to analyze the extracts using advanced analytical techniques, such as HPLC and GC, which could have provided a more detailed profile of the bioactive compounds present. The lack of bioassay-guided isolation of active compounds also limits our ability to identify specific components responsible for the observed biological activities. Future research incorporating animal models and clinical trials, along with comprehensive compound profiling and targeted isolation, is recommended to substantiate the therapeutic potential of P. benghalensis and clarify its mechanisms of action under biologically relevant conditions.
6. Conclusions
According to the findings obtained, it can be deduced that the methanol extracts derived from P. benghalensis stem bark and inflorescence demonstrated optimum antibacterial and antioxidant characteristics. Furthermore, these extracts were found to possess a notable amount of phenolic and flavonoid compounds. The findings from the in vitro study indicate that the ethyl acetate extracts derived from the stem bark and inflorescence of P. benghalensis may possess the ability to inhibit xanthine oxidase activity, a crucial enzyme in uric acid production. This finding indicates that these extracts may hold promise as a possible therapeutic intervention for gout. The detected biological effects of the extracts could be linked to the existence of diverse bioactive compounds like polyphenols, terpenoids, and flavonoids
Based on the observed antibacterial activity, extracts from the stem bark and inflorescence of P. benghalensis show promising potential as antibacterial agents. However, further studies, including in vivo and clinical evaluations, are essential to determine their efficacy against infections caused by Gram-positive and Gram-negative bacteria. Preliminary findings suggest that these extracts may be relevant for addressing bacterial infections associated with conditions such as urinary tract infections, dental issues, endocarditis, pneumonia, septicemia, otitis, meningitis, dysentery, and diarrhea. Rigorous research, including studies with animal models, is needed to elucidate their antibacterial mechanisms and validate their traditional medicinal uses. These investigations will deepen our understanding of P. benghalensis and contribute to the ongoing exploration of plant-based antibacterial agents. Additionally, potential anti-gout properties of the stem bark and inflorescence warrant further molecular and in vivo studies to assess their mechanisms and effectiveness in gout-related conditions.
Author Contributions
Conceptualization, J.P.; methodology, J.P.; software, J.P.; and S.K.; validation, J.P.; formal analysis, J.P.; and R.B.K.; investigation, N.J., J.P., M.J., D.C.G., and B.D.; resources, J.P. and R.B.K.; data curation, J.P., and N.J.; writing—original draft preparation, J.P.; writing—review and editing, J.P., and H.P.D.; supervision, J.P.; project administration, N.J. and J.P. All authors have read and agreed to the published version of the manuscript.
Funding
This research received no external funding.
Institutional Review Board Statement
Not applicable.
Informed Consent Statement
Not applicable.
Data Availability Statement
Data are available from the corresponding author, Jitendra Pandey, upon request.
Conflicts of Interest
The authors declare no conflicts of interest.
References
- Calixto, J.B. The role of natural products in modern drug discovery. An. Acad. Bras. 2019, 91, e20190105. [Google Scholar] [CrossRef] [PubMed]
- Unal, O.; Eraslan, E.C.; Uysal, I.; Mohammed, F.S.; Sevindik, M.; Akgul, H. Biological activities and phenolic contents of Rumex scutatus collected from Turkey. Fresenius Environ. Bull. 2022, 31, 7341–7346. [Google Scholar]
- Lamichhane, G.; Pandey, P.R. Regulatory aspects of nutraceuticals and functional foods in Nepal. Int. J. Nutraceuticals Funct. Foods Nov. Foods 2020, 2, 186–192. [Google Scholar]
- Ullah, F.; Ayaz, M.; Sadiq, A.; Ullah, F.; Hussain, I.; Shahid, M.; Yessimbekov, Z.; Adhikari-Devkota, A.; Devkota, H.P. Potential role of plant extracts and phytochemicals against foodborne pathogens. Appl. Sci. 2020, 10, 4597. [Google Scholar] [CrossRef]
- Mohammed, F.S.; Kına, E.; Sevindik, M.; Doğan, M.; Pehlivan, M. Antioxidant and antimicrobial activities of ethanol extract of Helianthemum salicifolium (Cistaceae). Indian J. Nat. Prod. Res. 2021, 12, 459–462. [Google Scholar]
- Balunas, M.J.; Kinghorn, A.D. Drug discovery from medicinal plants. Life. Sci. 2005, 78, 431–441. [Google Scholar] [CrossRef]
- Yuan, H.; Ma, Q.; Ye, L.; Piao, G. The traditional medicine and modern medicine from natural products. Molecules 2016, 21, 559. [Google Scholar] [CrossRef]
- Choudhury, A.; Singh, P.A.; Bajwa, N.; Dash, S.; Bisht, P. Pharmacovigilance of herbal medicines: Concerns and future prospects. J. Ethnopharmacol. 2023, 309, 116383. [Google Scholar] [CrossRef]
- Shahrajabian, M.H.; Sun, W. Five important seeds in traditional medicine, and pharmacological benefits. Seeds 2023, 2, 290–308. [Google Scholar] [CrossRef]
- Pandey, L.K.; Sharma, K.R. Analysis of phenolic and flavonoid content, α-amylase inhibitory and free radical scavenging activities of some medicinal plants. Sci. World J. 2022, 2022, 4000707. [Google Scholar] [CrossRef]
- Hemaiswarya, S.; Kumar, A.K.; Doble, M. Synergism between natural products and antibiotics against infectious diseases. Phytomedicine 2008, 15, 639–652. [Google Scholar] [CrossRef] [PubMed]
- Akinsulire, O.R.; Aibinu, I.E.; Adenipekun, T.; Adelowotan, T.; Odugbemi, T. In vitro antimicrobial activity of crude extracts from plants Bryophyllum pinnatum and Kalanchoe crenata. Afr. J. Tradit. Complement. Altern. Med. 2007, 4, 338–344. [Google Scholar] [CrossRef] [PubMed]
- Nascimento, G.F.; Locatelli, J.; Freitas, P.C.; Silva, G.L. Antibacterial activity of plant extracts and phytochemicals on antibiotic-resistant bacteria. Braz. J. Microbiol. 2000, 31, 247–256. [Google Scholar] [CrossRef]
- Tan, A. Novel 1, 2, 3-triazole compounds: Synthesis, in vitro xanthine oxidase inhibitory activity, and molecular docking studies. J. Mol. Struct. 2020, 1211, 128060. [Google Scholar] [CrossRef]
- Singh, J.V.; Bedi, P.M.; Singh, H.; Sharma, S. Xanthine oxidase inhibitors: Patent landscape and clinical development (2015–2020). Expert Opin. Ther. Pat. 2020, 30, 769–780. [Google Scholar] [CrossRef]
- Liu, L.; Zhang, L.; Ren, L.; Xie, Y. Advances in structures required of polyphenols for xanthine oxidase inhibition. Food Front. 2020, 1, 152–167. [Google Scholar] [CrossRef]
- Liang, G.; Nie, Y.; Chang, Y.; Zeng, S.; Liang, C.; Zheng, X.; Xiao, D.; Zhan, S.; Zheng, Q. Protective effects of Rhizoma smilacis glabrae extracts on potassium oxonate- and monosodium urate-induced hyperuricemia and gout in mice. Phytomedicine 2019, 59, 152772. [Google Scholar] [CrossRef]
- Kou, Y.Y.; Li, Y.F.; Xu, M.; Li, W.Y.; Yang, M.; Li, R.L. Effects of rupeng15 powder (rpp15) on monosodium urate crystal-induced gouty arthritis in rats. Evide. Based Complement. Alternat. Med. 2015, 2015, 527019. [Google Scholar] [CrossRef]
- Vasudeva, N.; Singla, P.; Das, S.; Sharma, S.K. Antigout and antioxidant activity of stem and root of Origanum majorana Linn. Am. J. Drug Discov. Dev. 2014, 4, 102–112. [Google Scholar] [CrossRef]
- Umamaheswari, M.; AsokKumar, K.; Somasundaram, A.; Sivashanmugam, T.; Subhadradevi, V.; Ravi, T.K. Xanthine oxidase inhibitory activity of some Indian medical plants. J. Ethnopharmacol. 2007, 109, 547–551. [Google Scholar] [CrossRef]
- Irawan, C.; Utami, A.; Styani, E.; Putri, I.D.; Putri, R.K.; Dewanta, A.; Ramadhanti, A. Potential of ethanolic extract from ripe Musa balbisiana Colla fruit using ultrasound-assisted extraction as an antioxidant and anti-Gout. Pharmacogn. J. 2021, 13, 1332–1340. [Google Scholar] [CrossRef]
- Daoudi, N.E.; Bouhrim, M.; Ouassou, H.; Bnouham, M. Medicinal plants as a drug alternative source for the antigout therapy in Morocco. Scientifica 2020, 2020, 8637583. [Google Scholar] [CrossRef] [PubMed]
- Uprety, Y.; Poudel, R.C.; Gurung, J.; Chettri, N.; Chaudhary, R.P. Traditional use and management of NTFPs in Kangchenjunga Landscape: Implications for conservation and livelihoods. J. Ethnobiol. Ethnomed. 2016, 12, 19. [Google Scholar] [CrossRef] [PubMed]
- Dangol, D.R. Economic uses of forest plant resources in western Chitwan, Nepal. Banko Janakari 2002, 12, 56. [Google Scholar] [PubMed]
- Aryal, S.; Adhikari, B.; Panthi, K.; Aryal, P.; Mallik, S.K.; Bhusal, R.P.; Salehi, B.; Setzer, W.N.; Sharifi-Rad, J.; Koirala, N. Antipyretic, antinociceptive, and anti-inflammatory activities from Pogostemon benghalensis leaf extract in experimental wister rats. Medicines 2019, 6, 96. [Google Scholar] [CrossRef]
- Dahiya, S.; Batish, D.R.; Singh, H.P. Ethnobotanical, phytochemical and pharmacological aspects of Bengal Pogostemon (Pogostemon benghalensis). J. Herbmed. Pharmacol. 2020, 9, 318–327. [Google Scholar] [CrossRef]
- Thakur, M.; Asrani, R.K.; Thakur, S.; Sharma, P.K.; Patil, R.D.; Lal, B.; Parkash, O. Observations on traditional usage of ethnomedicinal plants in humans and animals of Kangra and Chamba districts of Himachal Pradesh in North-Western Himalaya, India. J. Ethnopharmacol. 2016, 191, 280–300. [Google Scholar] [CrossRef]
- Dangol, D.R. Traditional uses of plants of common land habitats in Western Chitwan, Nepal. J. Inst. Agric. Anim. Sci. 2008, 29, 71. [Google Scholar]
- Padal, S.B.; Ramakrishna, H.; Devender, R. Ethnomedicinal studies for endemic diseases by the tribes of Munchingiputtu Mandal, Visakhapatnam district, Andhra Pradesh, India. Int. J. Med. Arom. Plants. 2012, 2, 45345–45349. [Google Scholar]
- Bhattarai, S.; Chaudhary, R.P.; Taylor, R.S. Ethno-medicinal plants used by the people of Nawalparasi District, Central Nepal. Our Nat. 2009, 7, 82–99. [Google Scholar] [CrossRef]
- Khadka, A.; Budha Magar, A.; Sharma, K.R. Chemical profiling and biological activities on nepalese medicinal plant extracts and isolation of active fraction of Nyctanthes arbor-tristis. Sci. World J. 2024, 2024, 5080176. [Google Scholar] [CrossRef] [PubMed]
- Taylor, R.S.; Manandhar, N.P.; Hudson, J.B.; Towers, G.H. Antiviral activities of Nepalese medicinal plants. J. Ethnopharmacol. 1996, 52, 157–163. [Google Scholar] [CrossRef] [PubMed]
- Dahiya, S.; Batish, D.R.; Singh, H.P. Pogostemon benghalensis essential oil inhibited the weed growth via causing oxidative damage. Rev. Bras. Bot. 2020, 43, 447–457. [Google Scholar] [CrossRef]
- Thoppil, J.E.; Tajo, A.; Minija, J.; Deena, M.J.; Sreeranjini, K.; Leeja, L.; Sivadasan, M.; Alfarhan, A.H. Antimicrobial activity of the essential oils of three species of Pogostemon. J. Environ. Biol. 2014, 35, 795–798. [Google Scholar]
- Premakumari, P.D.; Kumaraswamy, M.; Sarayu, M.G. Anti-inflammatory potential of essential oil from Pogostemon benghalensis (burm. f.) kuntze. using animal models. J. Adv. Sci. Res. 2020, 11, 92–99. [Google Scholar]
- Anjana, S.; Thoppil, J.E. Chemical composition of the essential oils of four Pogostemon spp. and their larvicidal activity against Aedes albopictus Skuse (Diptera: Culicidae). Int. J. Environ. Biol. 2013, 3, 26–31. [Google Scholar]
- Patel, M.S.; Antala, B.V.; Dowerah, E.; Senthilkumar, R.; Lahkar, M. Antitumor activity of Pogostemon benghalensis Linn. on ehrlich ascites carcinoma tumor bearing mice. J. Cancer Res. Ther. 2014, 10, 1071–1075. [Google Scholar] [CrossRef]
- Neupane, P.; Lamichhane, J. Estimation of total phenolic content, total flavonoid content and antioxidant capacities of five medicinal plants from Nepal. Vegetos 2020, 33, 360–366. [Google Scholar] [CrossRef]
- Umamaheswari, M.; Asokkumar, K.; Sivashanmugam, A.T.; Remyaraju, A.; Subhadradevi, V.; Ravi, T.K. In vitro xanthine oxidase inhibitory activity of the fractions of Erythrina stricta Roxb. J. Ethnopharmacol. 2009, 124, 646–648. [Google Scholar] [CrossRef]
- Palani, T.; Shobha, K.; Thirunavukkarasu, P.; Hari, R. In vitro and in silico antigout arthritic activities of ethanolic and aqueous stem extracts of Cissus quadrangularis—A TLR2 and TLR4 receptor approach. J. Appl. Pharm. Sci. 2018, 8, 15–22. [Google Scholar]
- Owen, P.L.; Johns, T. Xanthine oxidase inhibitory activity of northeastern North American plant remedies used for gout. J. Ethnopharmacol. 1999, 64, 149–160. [Google Scholar] [CrossRef] [PubMed]
- Neupane, S.; Bajracharya, S.; Thada, S.; Bakabal, A.; Khadka, R.B.; Devkota, H.P.; Pandey, J. Total phenolic and flavonoid contents, and preliminary antioxidant, xanthine oxidase inhibitory and antibacterial activities of fruits of lapsi (Choerospondias axillaris roxb.), an underutilized wild Fruit of Nepal. Appl. Sci. 2023, 13, 8945. [Google Scholar] [CrossRef]
- Bagale, R.; Acharya, S.; Gupta, A.; Chaudhary, P.; Chaudhary, G.P.; Pandey, J. Antibacterial and antioxidant activities of Prinsepia utilis royle leaf and seed extracts. J. Trop. Med. 2022, 2022, 3898939. [Google Scholar] [CrossRef] [PubMed]
- Sandhiya, U.; Manikandan, T.; Thavamurugan, S.; Kavipriya, M.R.; Pavithra, S.K.; Lakshmi Prabha, A.M. Profiling bioactive compounds of Pogostemon benghalensis (Burm. f.) Kuntze and its antibacterial activity. Vegetos 2024, 37, 144–154. [Google Scholar] [CrossRef]
- Pradeep, D.P.; Murugan, K. Comparative study on antioxidant activity of essential oils from Pogostemon benghalensis (Burm. f.) kuntze. and P. cablin (blanco) Benth. World J. Pharm. Res. 2018, 8, 1301–1313. [Google Scholar]
- Samydurai, P.; Saradha, M. Effects of various solvent on the extraction of antimicrobial, antioxidant phenolics from the stem bark of Decalepis hamiltonii Wight and Arn. Asian J. Res. Pharm. Sci. 2016, 6, 129–134. [Google Scholar]
- Tham, M.W.; Liew, K.C. Influence of different extraction temperatures and methanol solvent percentages on the total phenols and total flavonoids from the heartwood and bark of Acacia auriculiformis. Eur. J. Wood Wood Prod. 2014, 72, 67–72. [Google Scholar] [CrossRef]
- Yen, G.C.; Duh, P.D.; Tsai, C.L. Relationship between antioxidant activity and maturity of peanut hulls. J. Agric. Food Chem. 1993, 41, 67–70. [Google Scholar] [CrossRef]
- Pandey, Y.; Upadhyay, S.; Bhatt, S.S. Phytochemical constituent of some wild edible fruits of Sikkim Himalaya. J. Pharmacogn. Phytochem. 2018, 7, 1045–1047. [Google Scholar]
- Khatoniar, S.; Barooah, M.S.; Baruah, I.C. Qualitative and quantitative phytochemical assessment and antioxidant activity of selected green leafy vegetables of Assam. J. Pharmacogn. Phytochem. 2018, 7, 1762–1765. [Google Scholar]
- Parajuli, S.; Pun, N.T.; Parajuli, S.; Jamarkattel-Pandit, N. Antioxidant activity, total phenol and flavanoid contents in some selected medicinal plants of Nepal. J. Health Allied Sci. 2012, 2, 27–31. [Google Scholar] [CrossRef]
- Canadanovic-Brunet, J.M.; Djilas, S.M.; Cetkovic, G.S.; Tumbas, V.T. Free-radical scavenging activity of wormwood (Artemisia absinthium L) extracts. J. Sci. Food Agric. 2005, 85, 265–272. [Google Scholar] [CrossRef]
- Pimpliskar, M.R.; Jadhav, R.; Ughade, Y.; Jadhav, R.N. Preliminary phytochemical and pharmacological screening of Pogostemon benghalensis for antioxidant and antibacterial activity. Asian J. Pharm. Pharmacol. 2021, 7, 28–32. [Google Scholar] [CrossRef]
- Karle, B.A.; Sasawade, R.R. Study of antioxidant activity of some selected medicinal plants. Int. J. Res. Anal. Rev. 2019, 6, 645–647. [Google Scholar]
- Chanotiya, C.S.; Yadav, A.; Singh, A.K.; Mathela, C.S. Composition of the leaf and inflorescence essential oil of Pogostemon benghalensis Burm. F. from Kumaon. Nat. Prod. Commun. 2007, 2, 941–944. [Google Scholar] [CrossRef]
- Joshi, R.K. Volatile constituents of leaf, stem and flower of the traditional shrub Pogostemon plectranthoides Desf. from the Western Ghats, India. Nat. Prod. Res. 2021, 36, 411–413. [Google Scholar] [CrossRef]
- Quan, N.V.; Anh, L.H.; Lam, V.Q.; Takami, A.; Teschke, R.; Khanh, T.D.; Xuan, T.D. Anti-diabetes, anti-gout, and anti-leukemia properties of essential oils from natural spices Clausena indica, Zanthoxylum rhetsa, and Michelia tonkinensis. Molecules 2022, 27, 774. [Google Scholar] [CrossRef]
- Mutlu-Ingok, A.; Devecioglu, D.; Dikmetas, D.N.; Karbancioglu-Guler, F. Advances in biological activities of essential oils. Stud. Nat. Prod. Chem. 2022, 74, 331–366. [Google Scholar]
- Huang, C.Y.; Chang, Y.Y.; Chang, S.T.; Chang, H.T. Xanthine oxidase inhibitory activity and chemical composition of Pistacia chinensis leaf essential oil. Pharmaceutics 2022, 14, 1982. [Google Scholar] [CrossRef]
- Wang, S.Y.; Yang, C.W.; Liao, J.W.; Zhen, W.W.; Chu, F.H.; Chang, S.T. Essential oil from leaves of Cinnamomum osmophloeum acts as a xanthine oxidase inhibitor and reduces the serum uric acid levels in oxonate-induced mice. Phytomedicine 2008, 15, 940–945. [Google Scholar] [CrossRef]
- Bou-Salah, L.; Benarous, K.; Linani, A.; Bombarda, I.; Yousfi, M. In vitro and in silico inhibition studies of five essential oils on both enzymes human and bovine xanthine oxidase. Ind. Crops Prod. 2020, 143, 111949. [Google Scholar] [CrossRef]
- Lefebvre, T.; Destandau, E.; Lesellier, E. Selective extraction of bioactive compounds from plants using recent extraction techniques: A review. J. Chromatogr. A 2021, 1635, 461770. [Google Scholar] [CrossRef] [PubMed]
- Markom, M.; Hasan, M.; Daud, W.R.; Singh, H.; Jahim, J.M. Extraction of hydrolysable tannins from Phyllanthus niruri Linn.: Effects of solvents and extraction methods. Sep. Purif. Technol. 2007, 52, 487–496. [Google Scholar] [CrossRef]
- Essawi, T.; Srour, M. Screening of some Palestinian medicinal plants for antibacterial activity. J. Ethnopharmacol. 2000, 70, 343–349. [Google Scholar] [CrossRef] [PubMed]
- Lin, J.; Opoku, A.R.; Geheeb-Keller, M.; Hutchings, A.D.; Terblanche, S.E.; Jäger, A.K.; Van Staden, J. Preliminary screening of some traditional zulu medicinal plants for anti-inflammatory and anti-microbial activities. J. Ethnopharmacol. 1999, 68, 267–274. [Google Scholar] [CrossRef]
- Lodha, S.; Deshmukh, S. Phytochemical analysis and antimicrobial property of leaves of Pogostemon benghalensis (Burm. F.) Kuntze. Asian J. Microbiol. Biotechnol. Environ. Sci. 2020, 22, 71–76. [Google Scholar]
- Oussalah, M.; Caillet, S.; Lacroix, M. Mechanism of action of Spanish oregano, Chinese cinnamon and savory essential oils against cell membranes and cell walls of Escherichia coli O157:H7 and Listeria monocytogenes. J. Food. Prot. 2006, 69, 1046–1055. [Google Scholar] [CrossRef]
Disclaimer/Publisher’s Note: The statements, opinions and data contained in all publications are solely those of the individual author(s) and contributor(s) and not of MDPI and/or the editor(s). MDPI and/or the editor(s) disclaim responsibility for any injury to people or property resulting from any ideas, methods, instructions or products referred to in the content. |
© 2025 by the authors. Licensee MDPI, Basel, Switzerland. This article is an open access article distributed under the terms and conditions of the Creative Commons Attribution (CC BY) license (https://creativecommons.org/licenses/by/4.0/).